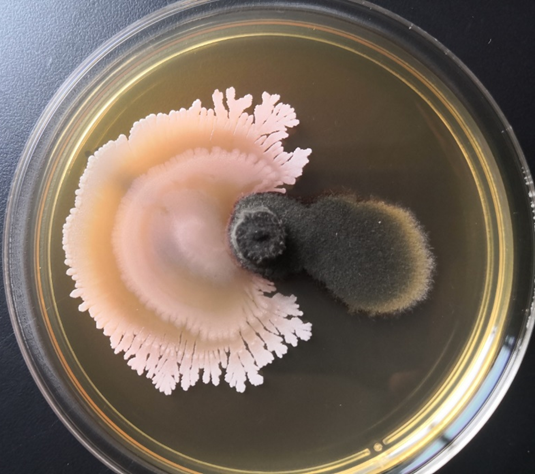

农作物生病了一般用什么药?大家耳熟能详的大部分都是化学农药,它们为我们人类粮食增产丰收发挥了巨大作用。但随着时间的推移,化学农药的滥用产生了环境污染、农药残留、食品污染、生态破坏等问题,细菌耐药性逐年增加,减少化学农药使用量和减轻农药污染,已成为农业可持续发展的当务之急。
什么是微生物农药?
微生物农药是指以细菌、真菌、病毒或经基因修饰的微生物活体为有效成分,它可以以菌治虫,也可以以菌治菌,还能以菌除草,这些微生物活体俗称生防菌。和传统化学农药相比,微生物农药对人、畜、农作物和自然环境安全,毒性较低,不易产生抗药性,在绿色农业中发挥了越来越重要的作用。
微生物农药包括了哪些种类?
按照微生物农药的功能可以分为微生物杀虫剂、杀菌剂、除草剂、生长调节剂等。微生物杀虫剂主要有苏云金芽孢杆菌、白僵菌、绿僵菌、淡紫拟青霉等。其中苏云金芽孢杆菌(简称Bt菌),是大家熟知的著名杀虫能手,它是1911年由贝尔奈(Berliner)从德国苏云金省一家面粉厂地中海粉螟上分离到的一种有很强杀虫力的细菌,并命名为苏云金芽孢杆菌。苏云金芽孢杆菌的防虫原理是菌株产生内毒素(伴胞晶体)和外毒素两类毒素,让害虫停止取食,害虫因饥饿、神经中毒等原因而死亡(图1)。Bt菌剂已成为目前世界上最成功、应用最广泛的微生物杀虫剂,替代了大量化学杀虫剂。截至2023年,我国批准使用的有效成分中含有Bt菌的杀虫剂产品已达249 个。

图1 苏云金芽孢杆菌对昆虫的侵染(图片来自网络)
微生物杀菌剂主要有细菌和真菌。细菌类杀菌剂占据了市场上微生物农药的主要市场,包括芽孢杆菌、类芽孢杆菌、放线菌等。常见的芽孢杆菌属微生物农药有枯草芽孢杆菌、解淀粉芽孢杆菌、贝莱斯芽孢杆菌(图2)等,类芽孢杆菌属微生物农药有多粘类芽孢杆菌等。放线菌类微生物农药主要是链霉菌,包括细黄链霉菌、弗氏链霉菌、不吸水链霉菌、娄彻氏链霉菌等。真菌类杀菌剂主要包括木霉、盾壳霉、粘帚霉、酵母等。
微生物杀菌剂的作用机制主要有以下几方面。(一)产生抗菌物质。包括抗生素类(如链霉素、四环素、抗菌蛋白、脂肽等)和细胞壁降解酶(破坏病原菌的细胞壁)等。(二)竞争作用。包括营养竞争(土壤中的氮、磷等营养物质)和空间竞争(通过占位使病原菌无法接触寄主植物的根系,减少侵染机会)。(三)诱导植物抗性。诱导植物产生抗性相关物质(如茉莉酸、水杨酸等),从而提高对病害、干旱、盐碱、高温等逆境的适应能力。(四)促进植物生长(产生赤霉素、细胞分裂素等植物生长激素,促进植物细胞的分裂和伸长),改善土壤环境(分解土壤中的有机物质,提高土壤肥力,促进土壤生物多样性)。
图2贝莱斯芽孢杆菌对番茄灰霉病病原菌的抑制(图片来源于本文作者)
还有一种病毒类新型杀菌剂—噬菌体。噬菌体是专门侵染细菌的一类病毒(图3),在环境中普遍存在,生物圈中数量高达 1031个,土壤中可达109个/ g土。可以说土壤中有多少种细菌,就对应有多少种噬菌体,因为噬菌体是寄生性的病毒,可以识别特定病原细菌,并进入细菌体内,高效裂解病原细菌,达到杀死病原细菌的目的。美国环保局分别在2005年和2011年批准了两款噬菌体生物农药产品,我们国家相应的产品还处于研发阶段。

图3 噬菌体(图片来自网络)
结语
微生物农药以安全、环保、高效的特性,正逐步成为发展绿色农业的主力军。但我们熟知并能利用的微生物农药种类相比浩瀚的微生物王国还是少之又少,许多技术难题也需要进一步去攻克,相信随着科技的发展,微生物农药将为构建绿色、生态、可持续的现代农业贡献更大的力量。
作者简介:卢美欢,陕西省微生物研究所副研究员,中国微生物学会会员,陕西省微生物学会理事,主要从事农业微生物资源开发利用及植物病害生物防治研究。





 扫码下载APP
扫码下载APP

 科普中国APP
科普中国APP
 科普中国
科普中国
 科普中国
科普中国